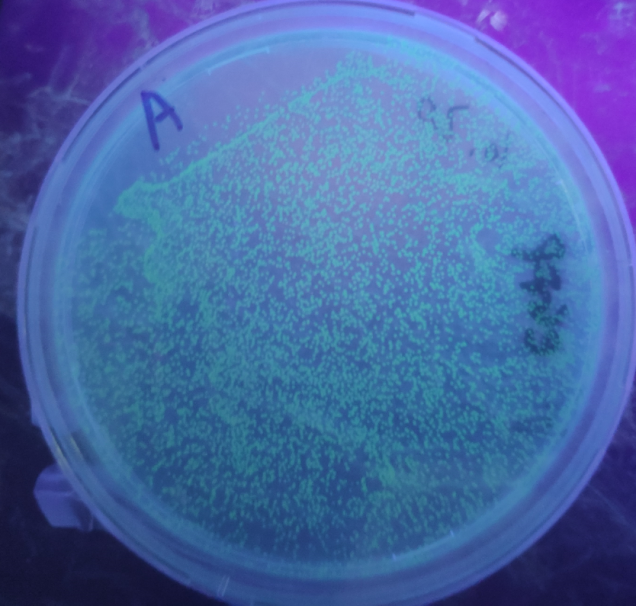

We characterized the efficiency of existing parts BBa_E0040 (green fluorescent protein as a reporter),BBa_I719005 (T7 promoter),BBa_J61104 (ribosome binding site) and BBa_B0012 (terminator) involved in the new composite part BBa_K3423005 designed by us.
Contribution
SUSTech_Shenzhen 2020 characterization
In part BBa_K3423005, protein anti-CRISPR-associated 1 (Aca1) is expressed by the T7 promoter, Aca1 will subsequently inhibit the anti-CRISPR promoter, so the gene expression downstream anti-CRISPR will be inhibited until Navitoclax (a compound that can inhibit Aca1 found by SUSTech_Shenzhen) is added artificially. Without the inhibition from Aca1, the expression of genes downstream anti-CRISPR promoters will increase significantly. Therefore, protein expression can be regulated artificially.
Aca1 was sufficiently expressed to inhibit a downstream promoter by T7 promoter; the ribosome binding site worked in the composite part because Aca1 is expressed; the transcription was terminated and it did not affect our composite part. All the existing parts worked in our newly designed regulated protein expression system. GFP was expressed as expected, which can directly reflect the efficiency of the regulatory role of Navitoclax in the composite part.
When Aca1 is mutated at its 44th amino acid (Arginine to alanine, Aca1R44A cannot inhibit the downstream acr promoter), the differential expression level of green fluorescent protein could be easily observed with naked eyes:
Figure 1. Aca1 inhibit the expression of green fluorescent protein compared to Aca1R44A which cannot inhibit acr promoter
Figure 2. eGFP expressed using acr promoter
The green fluorescence intensity regulated by navitoclax in part BBa_K3423005 is measured with a microplate reader:
Figure 3. The efficiency of Navitoclax measured with green fluorescence intensity using part BBa_K3423005